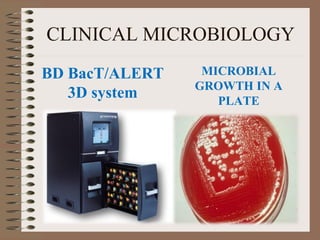
CLINICAL MICROBIOLOGY
BD BacT/ALERT
3D system
MICROBIAL
GROWTH IN A
PLATE
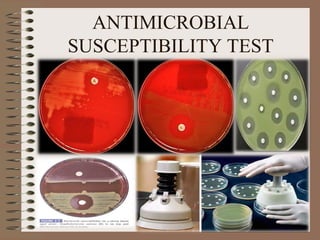
ANTIMICROBIAL
SUSCEPTIBILITY TEST

This document provides an overview of common diagnostic tests and activities performed in medical laboratories. It describes tests in various sections including serology, clinical chemistry, haematology, parasitology, and microbiology. Precise procedures and appropriate equipment are needed for accurate testing and results that clinicians rely on for 70% of medical decisions. Proper laboratory layout, trained personnel, quality control, and sterile techniques are crucial for reliable diagnostic results.